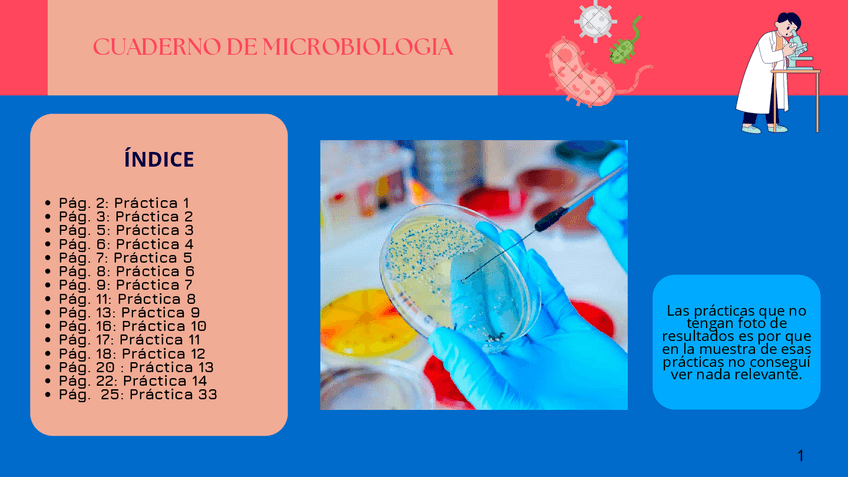
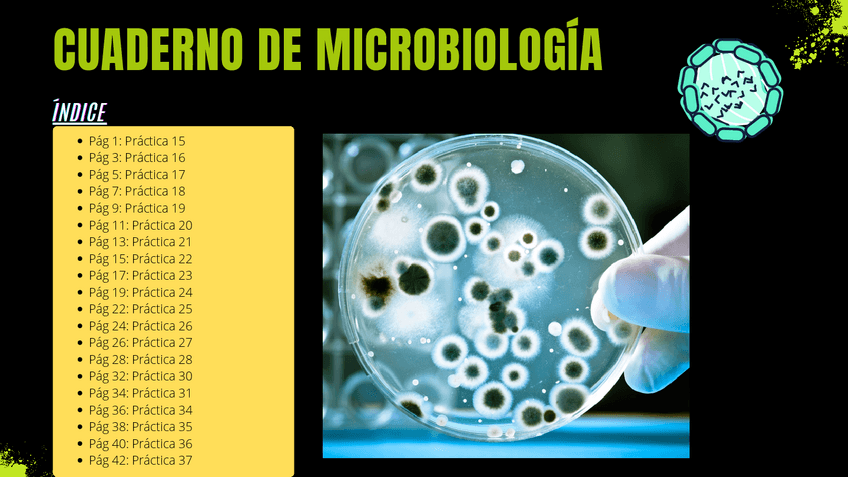

@Skay2003
Bio: Laboratorio clínico y biomédico
9 Publicaciones
55 Interacciones
0 Seguidores
0 Siguiendo
Lista de publicaciones de Skay2003
PRESENTACIÓN DE POWER POINT SOBRE MARCADORES TUMORALES ( info sacada sobre el tfg publicado en mi perfil)
He publicado nuevos practicas de Técnicas de inmunodiagnóstico: CUADERNO-DE-TECNICAS-DE-INMUNODIAGNOSTICO.pdf
He publicado nuevos practicas de Técnicas de análisis hematológico: CUADERNO-HEMATOLOGIA-FINAL.pdf
He publicado nuevos apuntes de 1º Bioquímica: DETERMINACIONES-EN-FARMACOLOGIA-Y-TOXICOLOGIA-CLINICA.pptx
He publicado nuevos apuntes de 1º Bioquímica: DETERMINACION-DE-ENZIMAS-GOT-Y-GAMMA-GT.pdf
He publicado nuevos apuntes de 1º Bioquímica: ANALISIS-BASICO-Y-SEDIMENTO-URINARIO-1.pdf
Cuaderno de prácticas de microbiología (laboratorio clínico y biomédico)
Cuaderno de prácticas de microbiología (laboratorio clínico y biomédico)